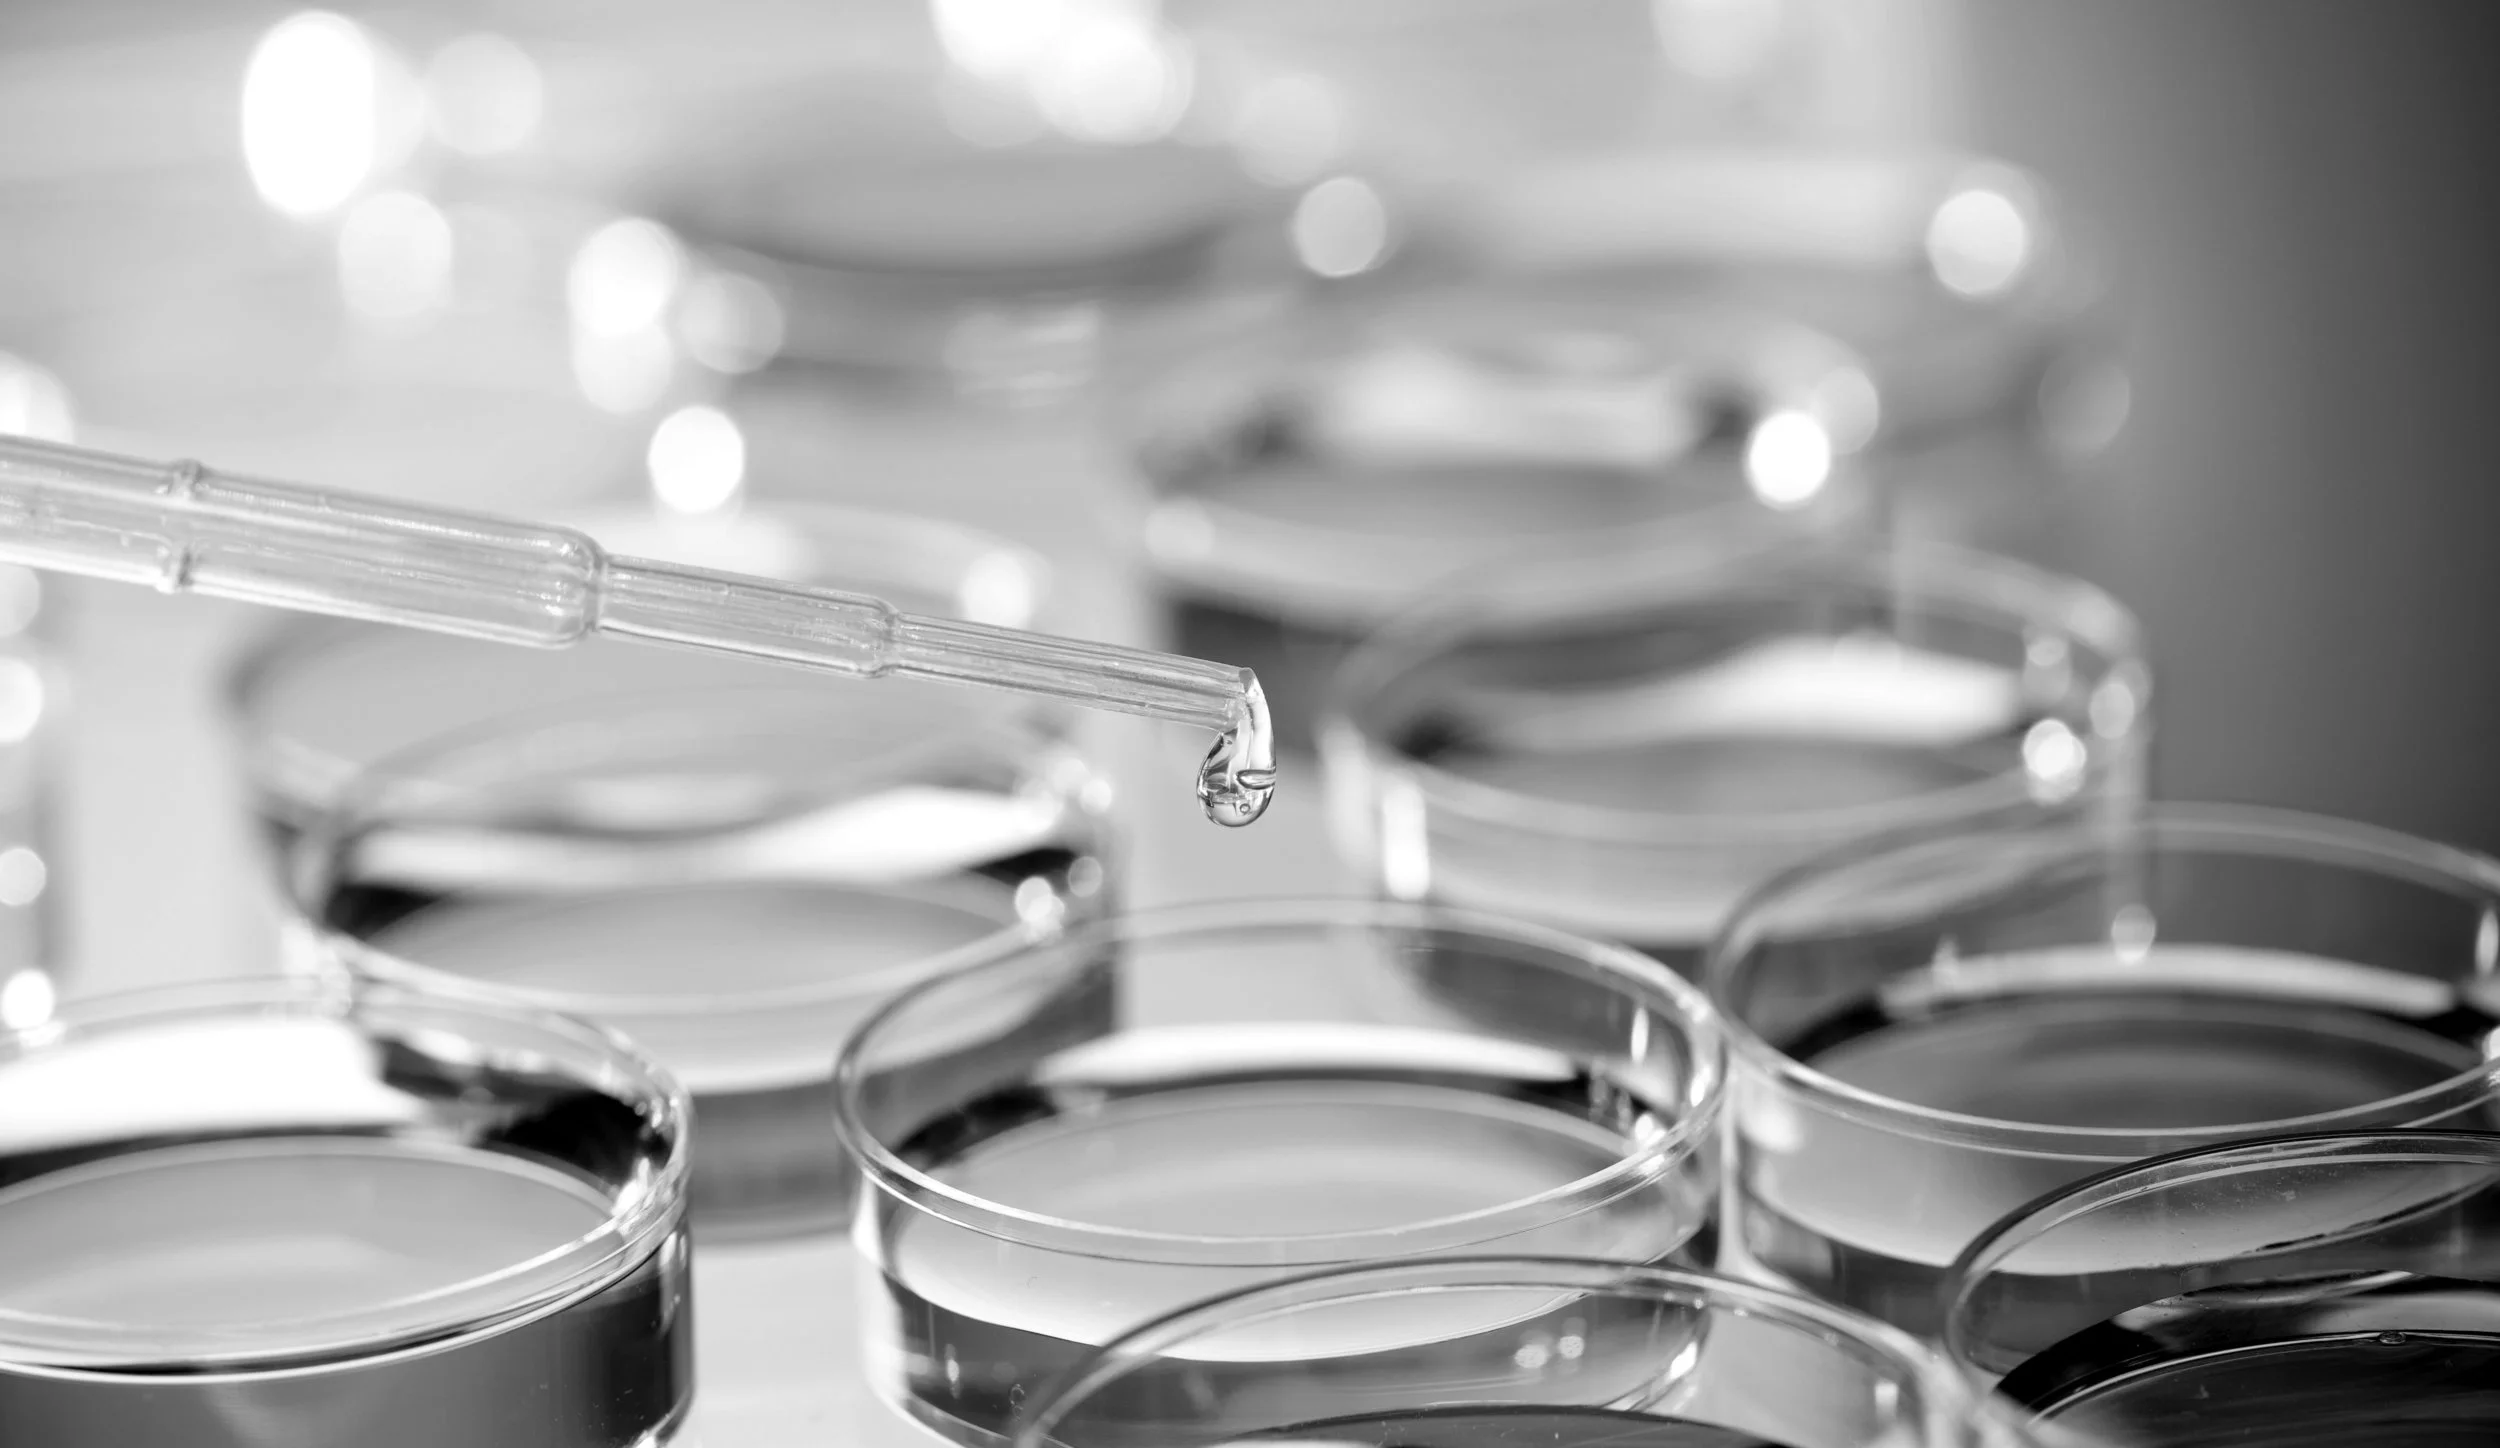
shutterstock_82837018_monochrome.jpg

Founded by award-winning architect Anthony Hayden in 1958, the Hayden Collective is one of the most respected architectural and interior design firms in the world.
Here is a description of your company. Hortor mauris condimentum nibh, ut fermentum massa justo sit amet risus. Nulla vitae elit libero, a pharetra augue. Morbi leo risus, porta ac consectetur ac, vestibulum at eros. Nullam id dolor id nibh ultricies vehicula ut id elit.